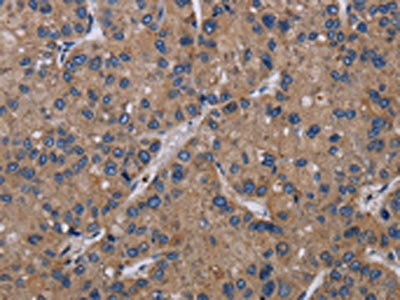

PVRL4 Antibody
-
中文名稱:PVRL4兔多克隆抗體
-
貨號:CSB-PA232987
-
規格:¥1100
-
圖片:
-
The image on the left is immunohistochemistry of paraffin-embedded Human colon cancer tissue using CSB-PA232987(PVRL4 Antibody) at dilution 1/40, on the right is treated with fusion protein. (Original magnification: ×200)
-
The image on the left is immunohistochemistry of paraffin-embedded Human liver cancer tissue using CSB-PA232987(PVRL4 Antibody) at dilution 1/40, on the right is treated with fusion protein. (Original magnification: ×200)
-
-
其他:
產品詳情
-
Uniprot No.:
-
基因名:
-
別名:DKFZp686K05193 antibody; EDSS1 antibody; Ig superfamily receptor LNIR antibody; Nectin 4 antibody; Nectin-4 antibody; poliovirus receptor-related 4 antibody; Processed poliovirus receptor-related protein 4 antibody; PRR4 antibody; pvrl4 antibody; PVRL4_HUMAN antibody
-
宿主:Rabbit
-
反應種屬:Human,Mouse
-
免疫原:Fusion protein of Human PVRL4
-
免疫原種屬:Homo sapiens (Human)
-
標記方式:Non-conjugated
-
抗體亞型:IgG
-
純化方式:Antigen affinity purification
-
濃度:It differs from different batches. Please contact us to confirm it.
-
保存緩沖液:-20°C, pH7.4 PBS, 0.05% NaN3, 40% Glycerol
-
產品提供形式:Liquid
-
應用范圍:ELISA,IHC
-
推薦稀釋比:
Application Recommended Dilution ELISA 1:2000-1:5000 IHC 1:50-1:200 -
Protocols:
-
儲存條件:Upon receipt, store at -20°C or -80°C. Avoid repeated freeze.
-
貨期:Basically, we can dispatch the products out in 1-3 working days after receiving your orders. Delivery time maybe differs from different purchasing way or location, please kindly consult your local distributors for specific delivery time.
-
用途:For Research Use Only. Not for use in diagnostic or therapeutic procedures.
相關產品
靶點詳情
-
功能:Seems to be involved in cell adhesion through trans-homophilic and -heterophilic interactions, the latter including specifically interactions with NECTIN1. Does not act as receptor for alpha-herpesvirus entry into cells.; (Microbial infection) Acts as a receptor for measles virus.
-
基因功能參考文獻:
- We suggest that Nectin-4 is a relevant prognostic factor and a therapeutic target in luminalB (HER2 negative) breast cancer. PMID: 28778498
- Nectin-4 promotes cell-cell adhesion/aggregation, migration, and proliferation of ovarian tumor cells. PMID: 28038455
- Nectin-4 is not only a BCSC marker but also a breast cancer metastasis marker PMID: 28600142
- This study suggests that PVRL4 is post-transcriptionally regulated by miR-128 and miR-31. PMID: 27507538
- High Nectin-4 expression is associated with neoplasms. PMID: 27013195
- We show that Measles virus gains entry into MCF7, DLD-1, and HTB-20 cancer cells through a PVRL4-mediated macropinocytosis pathway and identified the typical cellular GTPase and kinase involved. PMID: 28250131
- nectin-4 serves as a stimulatory co-receptor for the prolactin receptor by regulating the feedback inhibition of SOCS1 in the JAK2-STAT5a signaling pathway PMID: 28258213
- Nectin-4 is both a new promising prognostic biomarker and specific therapeutic target for Triple-negative breast cancers PMID: 27998973
- ADAM17 and ADAM10 cleave Nectin-4 and release soluble Nectin-4 (sN4). PMID: 28232483
- The data presented in this study suggested that nectin-4 may be a therapeutic target for systemic lupus erythematous through affecting the cell apoptosis PMID: 26617807
- Nectin-4 is critical for gallbladder cancer cell progression via PI3K/AKT pathway activation of Rac1. PMID: 26949052
- Nectin-4 expression, when compared with control group, was higher in endometriotic lesions of patients having ovarian endometriosis and peritoneal endometriosis. This difference was significant in the endometrium of patients having endometriosis. PMID: 27328518
- Transformation of breast cancer cells is dependent on PVRL4. PMID: 23682311
- Nectin-4 is a significant prognostic predictor, and may play a critical role in pancreatic cancer. Nectin-4 may be novel therapeutic target for pancreatic cancer. PMID: 25888293
- In airway epithelial cells, measles virus spread requires the nectin-4/afadin complex and is based on cytoplasm transfer between columnar cells. PMID: 25926640
- The present study described clinical investigation of the EDSS1 identified in a large consanguineous family; DNA sequence analysis revealed a novel homozygous nonsense mutation (181C>T, p.Asp61*) in the PVRL4 gene. PMID: 25529316
- Ovarian tissue expression and serum nectin 4 appear to be potential markers in ovarian cancer. PMID: 25019423
- Authors show that the same key residues in the BC and FG loops of nectin-4 govern binding to the measles virus attachment protein hemagglutinin (H) and cell entry, nectin-4 homodimerization, and heterodimerization with nectin-1. PMID: 25275122
- data outline a synergistic action of nectin-1 and -4 in the early steps of AJ formation and implicate this interaction in modulating the Rac1 signaling pathway PMID: 24577405
- Ablation of nectin4 binding compromises CD46 usage by a hybrid vesicular stomatitis virus/measles virus. PMID: 24335299
- Thus, while nectin-4 and CD46 interact functionally with the measles virus H protein beta4-beta5 hydrophobic groove, SLAM merely covers it. PMID: 23760251
- Data suggest that expression of nectin-4 is up-regulated in eutopic endometrium of patients with endometriosis compared with control subjects. PMID: 22926846
- We show that human nectin4 is fully functional as a canince distemper virus receptor. PMID: 23174504
- structure of the membrane-distal domain of nectin-4 in complex with measles virus hemagglutinin (MV-H; structure shows nectin-4 binds the MV-H beta4-beta5 groove exclusively via its N-terminal IgV domain; the contact interface is dominated by hydrophobic interactions PMID: 23202587
- crystals of nectin-4 diffracted to 1.8 A resolution and belonged to space group P2(1), with unit-cell parameters a = 33.1, b = 51.7, c = 56.9 A, beta = 94.7 degrees PMID: 22869128
- measles virus targets nectin-4 to emerge in the airways PMID: 22048310
- Measles virus infection reduced PVRL4 surface expression in MCF7 cells, a property that is characteristic of receptor-associated viral infections. PMID: 21901103
- The findings of study suggest that increased expression of Nectin-4 may indicate a worse prognosis in breast cancer patients. PMID: 21526486
- Sequence analysis revealed a homozygous missense mutation (c.635C>G; p.Pro212Arg) in the recently reported PVRL4 gene causing EDSS1 PMID: 21346770
- Ectoderma dysplasia-syndactyly syndrome. Second example of "nectinopathy". PMID: 21333831
- nectin 4 may serve as a potential biomarker that helps discriminate benign gynecologic diseases from ovarian cancer in a panel with CA125. PMID: 20959669
- Ectodermal dysplasia-syndactyly syndrome is the second known "nectinopathy" caused by mutations in a nectin adhesion molecule. PMID: 20691405
- the active form of TACE is overexpressed in breast tumors and may indicate that TACE is responsible for Nectin-4 shedding not only in vitro but also in vivo PMID: 15784625
- Nectin-4 was not detected in normal breast epithelium; by contrast Nectin-4 was expressed in ductal breast carcinoma. PMID: 17474988
- Nectin-4 might play a significant role in lung carcinogenesis, and it should be a new candidate serum and tissue biomarker, as well as a therapeutic target. PMID: 19679554
顯示更多
收起更多
-
相關疾病:Ectodermal dysplasia-syndactyly syndrome 1 (EDSS1)
-
亞細胞定位:Cell membrane; Single-pass type I membrane protein. Cell junction, adherens junction. Note=Colocalizes with AFDN at cadherin-based adherens junctions (PubMed:11544254).; [Processed poliovirus receptor-related protein 4]: Secreted. Note=The secreted form is found in breast tumor patients (PubMed:15784625).
-
蛋白家族:Nectin family
-
組織特異性:Predominantly expressed in placenta. Not detected in normal breast epithelium but expressed in breast carcinoma.
-
數據庫鏈接:
Most popular with customers
-
-
YWHAB Recombinant Monoclonal Antibody
Applications: ELISA, WB, IHC, IF, FC
Species Reactivity: Human, Mouse, Rat
-
Phospho-YAP1 (S127) Recombinant Monoclonal Antibody
Applications: ELISA, WB, IHC
Species Reactivity: Human
-
-
-
-
-